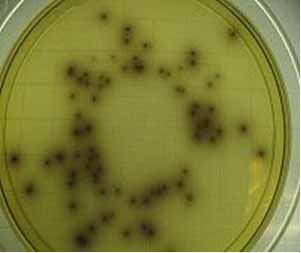
Listeria3

BS Đoàn Thị Thanh Vy
Giới thiệu
Nhiễm Listeria là một bệnh nhiễm trùng gây ra bởi trực khuẩn gram dương di động có tên khoa học là Listeria monocytogenes. Bệnh nhiễm Listeria tương đối hiếm và thường xảy ra ở thai phụ, trẻ sơ sinh, bệnh nhân lớn tuổi và người suy giảm miễn dịch.
Tần suất và tử suất
Tần suất nhiễm trùng Listeria vào khoảng 9,7 trường hợp trên 1 triệu dân ở Mỹ, 4 trên 1 triệu dân ở Canada. Hàng năm, có khoảng 2500 ca mới được báo cáo ở Mỹ, với tỉ lệ mắc bệnh cao vào những tháng mùa hè. Phụ nữ mang thai chiếm 27% số trường hợp mắc bệnh, hầu hết xảy ra ở tam cá nguyệt cuối. Những năm gần đây, tỷ lệ hiện mắc có xu hướng tăng đặc biệt là ở những người trên 60 tuổi. Tỷ lệ hiện mắc ở thai phụ và trẻ sơ sinh không đổi. Thai phụ có nguy cơ nhiễm Listeria cao hơn 20 lần so với phụ nữ khỏe mạnh, do những rối loạn nội tiết xảy ra lúc mang thai làm giảm sức đề kháng của cơ thể. 70% các trường hợp nhiễm bệnh - không tính các trường hợp chu sinh – xảy ra ở những bệnh nhân suy giảm miễn dịch mắc phải.
Tỷ lệ tử vong chiếm gần 20-40% ở trẻ sơ sinh nhiễm Listeria bùng phát sớm và ở trẻ bùng phát muộn là 0-20%. Tỷ lệ tử vong ở trẻ lớn là dưới 10%. Não úng thủy, chậm phát triển tâm thần là những di chứng thường gặp ở trẻ sống sót. Bệnh thường không ảnh hưởng nặng đến sức khỏe và tính mạng của mẹ.
Listeriose là bệnh nhiễm trùng ít gặp nhưng rất nguy hiểm do tỷ lệ tử vong cao, 25% đến 30%. Nhiều nước trên thế giới như Mỹ, Thụy Sĩ, nhất là ở Pháp, tỷ lệ nhiễm vi khuẩn này trong thực phẩm như sữa tươi và các sản phẩm chế biến từ sữa, thịt cá tươi sống và các sản phẩm của thịt cá, rau xanh...rất cao. Ở Việt Nam chưa có trường hợp nhiễm trùng nào được báo cáo là do Listeria gây ra.
Năm 2006, theo tổng kết của Phòng Kiểm Nghiệm Hóa Lý- Vi Sinh thực phẩm viện Pasteur TP.HCM, các mẫu hải sản đông lạnh có tỷ lệ nhiễm L.monocytogenes là 23/138 mẫu, chiếm 23,9%. Như vậy tỷ lệ xuất hiện của chủng vi khuẩn này cũng có khuynh hướng gia tăng theo thời gian ở nước ta và thường được tìm thấy trong các mẫu thực phẩm đông lạnh.

Hình 1. Listeria bắt màu gram dương dưới kính hiển vi thường
Nguồn: http://www.kimicontrol.com/microorg/Listeria%20monocytogenes.jpg
Bệnh học
Listeria monocytogenes là trực khuẩn gram dương, hình que, không tạo bào tử, sống được cả trong môi trường ái khí và kỵ khí, di động, có mặt khắp nơi trong môi trường. Có tất cả 7 loại Listeria và 11 chủng huyết thanh khác nhau được phát hiện, trong đó Listeria monocytogenes được xem là tác nhân chính cho các trường hợp nhiễm khuẩn qua thức ăn và các chủng huyết thanh 1a, 1b, 4b chiếm hầu hết trong các trường hợp bệnh.
Listeria có thể sống ở nhiệt độ 5-450C và độc tố tác dụng lên vùng điều hòa nhiệt của chúng hoạt động tốt nhất ở 370C.
L. monocytogenes có thể sống trong đất, gỗ và các chất hữu cơ đang phân hủy trong môi trường, đặc biệt con đường nhiễm Listeria phổ biến ở người là ăn phải các thức ăn bị nhiễm. Listeria hiện diện ở thịt nấu không chín, bơ sữa, các loại rau xanh rửa không sạch và hải sản. Listeria không phải là vi khuẩn thường trú trên cơ thể người do đó khi nhiễm có thể dẫn đến biểu hiện bệnh. Ở Mỹ và các nước phát triển, nhiễm Listeria thường gặp khi ăn các loại thức ăn nhanh chế biến sẵn như bánh mì kẹp thịt, phô mai, bơ, thịt cá xông khói và các loại khác.

Hình 2. Listeria dưới kính hiển vi điện tử
Nguồn: http://www.embraceaustralia.com/wp-content/uploads/2009/08/listeria_485-300x193.jpg
Cơ chế bệnh sinh
Phần lớn khi trực khuẩn Listeria xâm nhập vào cơ thể đều bị hệ miễn dịch của cơ thể bắt giữ. Đầu tiên là các miễn dịch tại chỗ ở đường tiêu hóa, pH acid ở dạ dày và các đại thực bào. Tuy nhiên những vi khuẩn trốn thoát được sẽ ẩn nấp trong tế bào ký chủ, ở đây nó thoát khỏi sự tấn công của hệ miễn dịch và sinh sôi phát triển trong tế bào ký chủ.
Để xâm nhập vào các đại thực bào, Listeria phô bày các D-galactose trên bề mặt lớp teichoic acid của chúng, điều này kích thích cơ chế thực bào của các đại thực bào. Các đại thực bào sẽ gắn kết lớp D-galactose này với thụ thể có bản chất polysaccharide của chúng. Vào được bên trong đại thực bào, nó sẽ ký sinh nội bào như Rickettsia và sử dụng các nguyên liệu của ký chủ để tổng hợp vỏ, nhân cho các Listeria mới và thông qua độc tố Hemolysin nó phá hủy đại thực bào và thoát ra ngoài và đi tìm các tế bào mới. Ở ngoài cơ thể ký chủ, Listeria di chuyển nhờ lông roi. Nhưng ở 370C, lông roi này không hoạt động được và rụng mất, do đó Listeria phải sử dụng các nguyên liệu từ bộ xương tế bào ký chủ để tổng hợp đuôi actin cho mình.
Biểu hiện lâm sàng
Phụ nữ mang thai có thể bị nhiễm bất kỳ giai đoạn nào của thai kỳ, nhưng thường gặp nhất là ở ba tháng cuối, có thể biểu hiện bằng rối loạn đường tiêu hóa như buồn nôn, nôn, tiêu chảy, sốt, cảm giác khó chịu, đau lưng và nhức đầu. Nhiều phụ nữ mang thai nhiễm Listeria không triệu chứng ở dạ dày, ruột non và âm đạo, họ thải Listeria theo phân và trở thành người mang mầm bệnh. Mẹ nhiễm Listeria ba tháng đầu có thể bị sẩy thai tự nhiên. Nhiễm Listeria ba tháng giữa, ba tháng cuối có thể dẫn đến thai chậm tăng trưởng, sinh non, vỡ ối sớm, nhiễm trùng ối. Nhiễm trùng cho thai nhi có thể gây ra do Listeria từ máu mẹ qua bánh nhau, dây rốn hoặc nhiễm trùng ngược dòng từ âm đạo của mẹ qua màng ối vỡ.
Hai biểu hiện lâm sàng ở trẻ sơ sinh nhiễm Listeria:
- Bùng phát sớm (xảy ra trước 5 ngày đầu sau sinh)
- Bùng phát muộn (xảy ra 5 ngày sau sinh)
Nhiễm Listeria ở trẻ em thường dẫn tới nhiễm trùng huyết và viêm màng não. Ở trẻ sơ sinh biểu hiện nhiễm Listeria muộn thường có viêm màng não mủ đi kèm. Listeria thường gây ra những ổ áp xe nhỏ hoặc u hạt ở các cơ quan, đặc biệt là gan. Nhiễm Listeria ở trẻ em thường biểu hiện là những hồng ban mụn mủ khắp cơ thể.

Hình 3. Biểu hiện nhiễm Listeria ở miệng
Nguồn: http://farm1.static.flickr.com/103/292809333_e8d2e49c8d.jpg
Biểu hiện chung:
- Rối loạn hô hấp: thở nhanh, thở rên, co kéo cơ hô hấp phụ, khó thở
- Rối loạn điều hòa nhiệt: có thể sốt hoặc giảm thân nhiệt
- Chán ăn
- Lơ mơ hoặc bứt rứt
- Co giật
- U hạt ở trẻ em: nền là hồng ban, phía trên là các u hạt viêm
Cận lâm sàng
- Cấy máu
- Cấy dịch não tủy
- Cấy dịch tiết đường hô hấp
- Xét nghiệm mô học hoặc cấy dịch tiết ở các hồng ban
- Có thể cấy dịch tiết ở nơi khác như: khớp, dịch màng tim, dịch màng phổi, dịch ối, dịch dạ dày…
- Siêu âm, CT, MRI phát hiện các ổ áp xe ở gan, não
Hình 4. Listeria mọc trên thạch agar
Nguồn: http://upload.wikimedia.org/wikipedia/en/thumb/2/22/LSA.jpg/200px-LSA.jpg
Điều trị
- Chăm sóc nâng đỡ: lau mát hạ sốt, uống nhiều nước, theo dõi nhiệt độ, nhịp thở, cân bằng nước điện giải.
- Kháng sinh: Listeria không nhạy với Cephalosporin, nhưng nhạy với penicillin và ampicillin.
a) Phác đồ 1: Ampicillin+aminoglycoside: Ức chế việc tổng hợp mucopeptide của thành tế bào vi khuẩn, dẫn đến tiêu diệt vi khuẩn.
Liều Ampicilin:
- Người lớn: 1-3 g IV mỗi 3-4h; không quá 12g / ngày
- Trẻ em: 25-100 mg/kg tiêm tĩnh mạch chậm (viêm màng não liều cao hơn) lặp lại mỗi 6h.
Liều Gentamycin:
- Người lớn: 3-5mg/kg IV chia làm 3 lần
- Trẻ em:
- Tấn công: 4mg/kg IV chia làm 1 lần, 2lần, 3 lần tùy tuổi trẻ em
- Duy trì: 2,5-3mg/kg truyền tĩnh mạch trong 30 phút
b) Phác đồ 2: Sulfamethoxazole và Trimethoprim (Bactrim, Cotrim, Septra): Ức chế tổng hợp dihydrofolic acid từ đó ức chế sự phát triển vi khuẩn, dùng cho người dị ứng ampicillin.
- Người lớn: 15-20 mg/kg/ngày (tùy vào thành phần Trimethoprim) đường uống hoặc đường tiêm mạch chia làm 4 lần/ngày
- Trẻ em:
- < 2 tháng tuổi: không được dùng
- ≥ 2 tháng tuổi: 8-12 mg/kg/ngày (tùy vào thành phần Trimethoprim) tiêm tĩnh mạch chia làm 4 lần/ngày
c) Phác đồ 3: Penicillin G: dùng thay thế ampicillin
- Người lớn: 15-20 triệu đơn vị/ ngày tiêm TM chia làm 4 hoặc 6 lần/ngày
- Trẻ em: 250.000-400.000 UI/kg/ngày tiêm TM chia làm 4 hoặc 6 lần/ngày
Dự phòng
- Rửa tay sạch sẽ trước khi nấu nướng và trước khi ăn
- Giữ thức ăn được che đậy cẩn thận
- Nếu không ăn liền, phải để thức ăn vào tủ lạnh trong vòng một tiếng sau nấu
- Giữ lạnh thịt sống, cá sống trước khi nấu
- Giữ tủ lạnh sạch sẽ và nhiệt độ dưới 50C
- Xem xét kỹ hạn sử dụng
- Không được nêm nếm thức ăn bằng các dụng cụ đã sử dụng cho thức ăn sống nếu chưa được rửa lại
- Rửa kỹ rau và trái cây trước khi ăn
- Đun sôi nước và nấu chín kỹ thức ăn trước khi ăn
Tài liệu tham khảo
1. Abrishami, S.H., B.D. Tall, T.J. Bruursema, P.S. Epstein, and D.B. Shah. 1994. "Bacterial adherence and viability on cutting board surfaces". Journal of Food Safety. 14: 153-172.
2. Bayles, D.O., and B.J. Wilkinson. 2000. "Osmoprotectants and cryoprotectants for Listeria monocytogenes". Letters in Applied Microbiology. 30: 23-27.
3. Allerberger, F. 2003. "Listeria: growth, phenotypic differentiation and molecular microbiology". FEMS Immunology and Medical Microbiology. 35: 183-189.
4. Harris J. Listeria monocytogenes: which of your patients is not at risk? Australian Nursing Journal 2008; 16(1): 26-8.
5. Weinstein K, Ortiz J. Listeria Monocytogenes 2008. http://emedicine.medscape.com/article/220684-print.